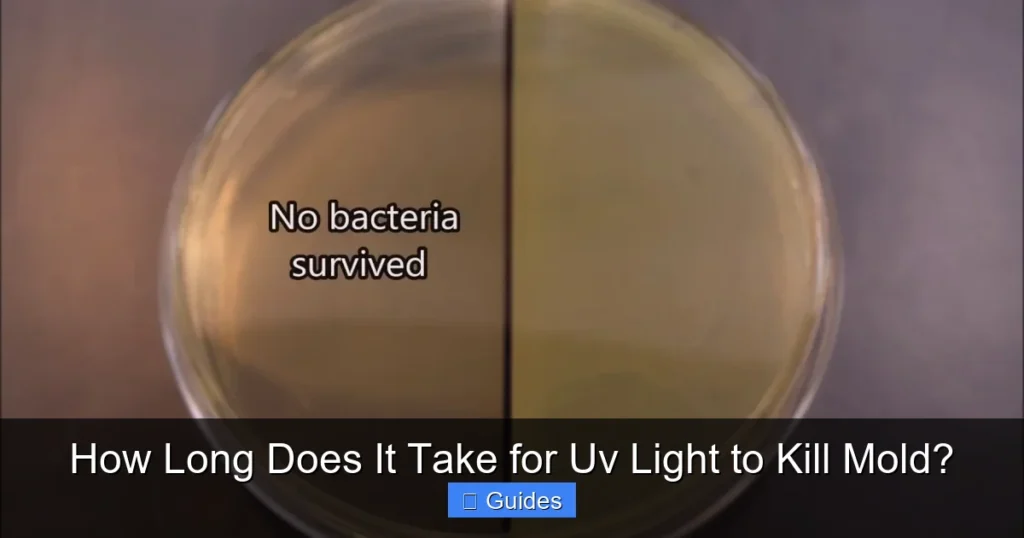
How Long Does It Take for Uv Light to Kill Mold?

UV light, specifically UV-C, can effectively inactivate mold spores and kill surface mold, but it’s not an instant solution. The time it takes for UV light to kill mold varies significantly based on UV intensity, exposure duration, distance from the mold, and the type of mold itself. While great for airborne spores and treating surfaces, UV light cannot penetrate porous materials, making it insufficient for deep-seated mold infestations. Always use UV-C with extreme caution due to health risks.
Mold. Just hearing the word can send shivers down your spine, conjuring images of fuzzy, discolored patches in damp corners of your home. It’s not just an eyesore; mold can pose significant health risks, trigger allergies, and even damage your property. So, when you’re facing a mold problem, you naturally look for effective solutions.
One technology that often comes up in discussions about sanitization and germ-killing is ultraviolet (UV) light. You might have heard about its use in hospitals, water purification, and air purifiers. But when it comes to those stubborn mold colonies, many homeowners wonder: how long does it take for UV light to kill mold? Is it a quick fix, or a prolonged battle? Let’s dive deep into the science and practicalities of using UV light against mold.
Understanding the effectiveness and limitations of UV light is crucial before you consider it for your mold remediation efforts. We’ll explore what UV light is, how it works, what factors influence its ability to kill mold, and most importantly, what realistic expectations you should have regarding the time it takes. Our goal is to equip you with the knowledge to make informed decisions about tackling mold in your environment.
Key Takeaways
- UV-C Light is Germicidal: UV-C light (short-wave ultraviolet light) works by damaging the DNA and RNA of mold cells, rendering them unable to reproduce and effectively “killing” or inactivating them.
- Variable Exposure Time: There is no single answer to “how long does it take for UV light to kill mold.” It can range from minutes to hours, depending on factors like UV intensity, distance, exposure duration, and the specific mold species and its growth stage.
- Surface vs. Porous Materials: UV light is effective at killing mold spores and growth on non-porous surfaces and in the air. However, it cannot penetrate porous materials like drywall, wood, or fabric, meaning it won’t eradicate mold hidden deep within these structures.
- Not a Standalone Solution for Infestations: For significant mold infestations, UV light should be considered a supplementary tool, not a primary method of remediation. It’s best used after physical removal of visible mold and for ongoing air quality control.
- Crucial Safety Precautions: UV-C light is harmful to humans and pets. Direct exposure can cause severe eye damage and skin burns. Always use protective gear and ensure no living beings are present during UV-C operation.
- Factors Affecting Efficacy: Key factors include the wattage and type of UV lamp, its proximity to the mold, the cleanliness of the surface (dust can block UV rays), and continuous versus intermittent exposure.
Quick Answers to Common Questions
Can UV light kill black mold?
Yes, UV-C light can inactivate black mold (Stachybotrys chartarum) spores and kill its surface growth, similar to other mold species, by damaging its DNA. However, it cannot penetrate surfaces to eradicate mold hidden within materials.
Is UV light enough to get rid of a mold problem?
No, UV light is generally not enough to completely get rid of an existing mold problem, especially if it’s a significant infestation. It’s best used as a preventative measure or a supplementary tool for surface disinfection and airborne spore reduction after physical mold removal.
Does UV light remove mold stains or odors?
UV light does not physically remove mold stains or the musty odors produced by mold. While it kills the mold, the dead mold cells and their byproducts can still cause discoloration and emit odors. Physical cleaning is required to remove stains and odors.
Can I use a UV flashlight to kill mold?
While some UV flashlights emit UV-C, many consumer models are not powerful enough or designed for the sustained, intense exposure required to effectively kill mold. They are often for detecting pet stains or counterfeit currency. Specialized germicidal UV-C wands or lamps are needed for mold inactivation.
How close does UV light need to be to kill mold?
UV light’s effectiveness significantly decreases with distance. For optimal mold killing, a UV-C lamp needs to be as close as possible to the mold, ideally within a few inches, to deliver sufficient intensity for inactivation in a reasonable timeframe.
📑 Table of Contents
- Understanding Mold and Its Dangers
- How UV Light Works Against Microorganisms
- The Efficacy of UV Light on Mold: What the Science Says
- Practical Applications: Where UV Light Can Be Used for Mold Control
- The Real Answer: How Long Does It Take for UV Light to Kill Mold?
- Limitations and Safety Precautions of UV Light
- Conclusion
Understanding Mold and Its Dangers
Before we talk about killing mold, let’s quickly understand our opponent. Mold is a type of fungus that grows in moist conditions, both indoors and outdoors. It reproduces by releasing tiny spores into the air, which can travel and settle on new surfaces, given the right conditions (moisture, nutrients, and temperature). Common indoor molds include Cladosporium, Penicillium, Aspergillus, and Stachybotrys chartarum (often called black mold).
Why Mold is a Problem
Mold isn’t just an ugly house guest. It can cause a range of problems:
- Health Issues: For many people, exposure to mold can trigger allergic reactions like sneezing, runny nose, red eyes, and skin rash. Asthma attacks can worsen, and individuals with weakened immune systems or chronic lung illnesses are at higher risk of mold infections.
- Structural Damage: Mold literally eats away at organic materials like wood, drywall, insulation, and fabrics. Over time, this can compromise the structural integrity of your home, leading to costly repairs.
- Unpleasant Odors: Mold often produces a distinct, musty smell that can permeate your home, making it an uncomfortable place to live.
Because of these issues, finding effective ways to control and eradicate mold is essential for maintaining a healthy and safe living environment. This is where the potential of UV light comes into play, but with specific caveats.
How UV Light Works Against Microorganisms
UV light is a form of electromagnetic radiation, just like visible light, radio waves, or X-rays. What makes UV light unique is its shorter wavelength and higher energy, which can have profound effects on organic matter, including microorganisms like mold, bacteria, and viruses.

Visual guide about How Long Does It Take for Uv Light to Kill Mold?
Image source: enviroklenz.com
The Spectrum of UV Light
UV light is categorized into three main types based on wavelength:
- UV-A (315-400 nm): The least energetic, primarily responsible for tanning and skin aging. It largely passes through the atmosphere.
- UV-B (280-315 nm): More energetic, causes sunburn and contributes to skin cancer. Most of it is absorbed by the ozone layer.
- UV-C (100-280 nm): The most energetic and dangerous to living organisms. Fortunately, the Earth’s ozone layer completely absorbs natural UV-C from the sun. Artificial UV-C is what we use for germicidal purposes.
UV-C: The Germicidal Powerhouse
When people talk about using UV light to kill mold or other pathogens, they are almost exclusively referring to UV-C light. UV-C light, particularly at wavelengths around 254 nanometers, is germicidal. This means it has the ability to inactivate microorganisms. Here’s how it works:
UV-C photons are absorbed by the DNA and RNA of mold spores and cells. This absorption creates pyrimidine dimers, which are kinks or breaks in the genetic code. These DNA and RNA damages prevent the mold cells from replicating, essentially stopping them from reproducing and spreading. While the mold cell itself might not instantly disintegrate, it becomes “inactivated” or “killed” in the sense that it can no longer grow, spread, or pose a biological threat. This is the fundamental mechanism that allows UV light to kill mold effectively.
The Efficacy of UV Light on Mold: What the Science Says
So, we know UV-C light can damage mold’s DNA. But how effective is this in a real-world scenario, and specifically, how long does it take for UV light to kill mold? The science supports UV-C as a powerful tool, but its efficacy isn’t absolute or instantaneous, and several factors come into play.
Factors Affecting UV’s Mold-Killing Power
The success of using UV light to kill mold depends on a combination of critical factors:
- UV-C Intensity: This is arguably the most important factor. A higher intensity UV-C lamp emits more photons, leading to faster and more effective inactivation. Intensity is measured in microwatts per square centimeter (µW/cm²).
- Exposure Duration: The longer the mold is exposed to UV-C light, the more damage accumulates in its DNA, increasing the likelihood of inactivation. This directly relates to the question of how long it takes for UV light to kill mold.
- Distance from the Source: UV-C light intensity diminishes significantly with distance. The closer the mold is to the UV-C lamp, the more effective the treatment will be. This follows the inverse square law.
- Airflow and Air Exchange Rates: For airborne spores, effective air circulation is vital to ensure spores pass through the UV-C treatment zone.
- Mold Species and Stage: Some mold species might be slightly more resistant than others. Also, dormant spores might require different exposure than actively growing mycelium.
- Surface Cleanliness: Dust, dirt, or debris on a surface can shield mold from UV-C rays, significantly reducing effectiveness. UV light cannot penetrate these barriers.
Spores vs. Active Colonies
UV light is generally very effective at inactivating airborne mold spores. These tiny particles, when suspended in the air and exposed to UV-C, are quickly rendered harmless. This is why UV-C lamps are common in HVAC systems and air purifiers.
For active mold colonies growing on surfaces, UV-C can also kill the surface layer of mold. However, here’s a critical distinction: UV-C light has very poor penetration. It can’t go through opaque objects, nor can it penetrate deep into porous materials like drywall, wood, fabric, or carpet. This means if mold has roots or mycelium embedded within these materials, UV light will only kill the exposed surface growth, leaving the deeper mold intact to potentially regrow. This is a fundamental limitation when considering how long it takes for UV light to kill mold in a comprehensive sense.
Surface vs. Airborne Mold
Think of it this way: UV-C is excellent for disinfecting the air and non-porous surfaces that can be directly and continuously exposed. For example, sterilizing laboratory equipment or the coils of an HVAC unit. For a visible patch of mold on a painted wall, UV-C can kill what’s on the surface, but it won’t address any mold that might be growing behind the wall or deeper within the drywall itself.
Practical Applications: Where UV Light Can Be Used for Mold Control
Given its strengths and weaknesses, where does UV light fit into a practical mold control strategy? It’s primarily a tool for prevention and supplementary treatment rather than a standalone solution for major infestations.
HVAC Systems and Air Quality
One of the most common and effective uses of UV-C light for mold control is within heating, ventilation, and air conditioning (HVAC) systems. UV-C lamps are installed near the evaporator coils and in the return air ducts. Here’s why this works well:
- Coil Sterilization: The evaporator coil is often damp and cool, making it a prime breeding ground for mold, mildew, and bacteria. A UV-C light continuously shining on the coil keeps it clean, preventing mold growth that could reduce efficiency and spread spores through the air.
- Air Purification: As air circulates through the HVAC system, airborne mold spores (and other pathogens) pass through the UV-C light zone. The UV-C inactivates these spores, reducing their concentration in the air distributed throughout your home. This is a great way to use UV light to kill mold spores before they settle.
Portable UV-C Devices
Various portable UV-C wands and lamps are available for consumer use. These can be helpful for:
- Surface Disinfection: For non-porous surfaces like countertops, bathroom tiles, or tools, a portable UV-C device can be used to sanitize and kill surface mold or spores after initial cleaning.
- Small, Contained Areas: In small, unoccupied spaces where direct exposure can be maintained, these devices can help with mold issues. However, remember the safety warnings!
It’s important to stress that these devices often have lower intensity than industrial-grade systems and require proper, prolonged exposure to be effective. They are not designed to tackle large, established mold infestations.
The Real Answer: How Long Does It Take for UV Light to Kill Mold?
Now to the burning question: exactly how long does it take for UV light to kill mold? The truth is, there’s no single, universal answer. It’s not a matter of “X minutes and it’s gone.” The time required is highly variable and depends on the specific factors we discussed earlier.
It’s Not a Simple “X” Minutes
To give you a rough idea, laboratory studies under controlled conditions might show inactivation of mold spores in seconds to a few minutes when exposed to high-intensity UV-C at very close range. However, real-world applications are far less controlled. For actively growing mold on a surface:
- High-intensity, close-range exposure: You might see surface mold inactivation in minutes to a few hours. This would typically require a powerful, dedicated UV-C lamp held very close to the mold.
- Lower intensity or further distance: The time required can extend to several hours or even continuous exposure for days to achieve significant reduction. Think of HVAC systems where the UV lamp continuously shines on the coil, preventing growth over time.
For airborne mold spores, the effectiveness is about the duration of exposure as they pass through the UV-C field. In an HVAC system, spores are exposed for a fraction of a second during each pass, but constant air circulation means they are repeatedly exposed, leading to cumulative damage and effective reduction over time. This continuous, low-level exposure is often how UV light helps to kill mold in the air.
It’s vital to consult the manufacturer’s specifications for any UV-C device you use. They usually provide guidance on effective exposure distances and times for killing various pathogens, including mold.
Continuous Exposure vs. Spot Treatment
For comprehensive mold control with UV light, continuous or very regular exposure is often more effective than a one-time spot treatment. In HVAC systems, the lamps run continuously. For surface mold, you might need to leave a portable UV-C lamp focused on the area for an extended period, perhaps overnight, ensuring no one enters the space. However, remember the limitations regarding penetration – this only addresses surface mold.
Importance of Surface Preparation
For UV light to kill mold on a surface, the mold must be directly exposed to the UV-C rays. Any dust, dirt, paint, or other debris on top of the mold will act as a shield. Therefore, before attempting to use UV-C on a visible mold patch, it’s crucial to clean the surface thoroughly to remove any obstructions. This ensures the UV-C can directly hit the mold cells, maximizing its effectiveness and reducing the time needed for inactivation.
Limitations and Safety Precautions of UV Light
While UV-C light is a powerful tool against mold, it comes with significant limitations and serious safety concerns that cannot be overstated.
UV Light’s Inability to Penetrate Surfaces
This is perhaps the biggest limitation. UV-C light cannot penetrate opaque objects. If mold is growing inside a wall, under flooring, behind wallpaper, or deep within a porous material, UV light simply won’t reach it. It will only kill the visible, exposed surface mold. For widespread or deeply rooted mold infestations, physical removal (mold remediation) by a professional is almost always necessary. UV light cannot replace the need to remove mold-infested materials.
Health Risks to Humans and Animals
UV-C light is extremely harmful to living tissue. Direct exposure can cause:
- Eye Damage: Even brief exposure can lead to photokeratitis, a painful “sunburn” of the cornea, often described as having sand in your eyes. Repeated exposure can contribute to cataracts and other long-term eye problems.
- Skin Burns: UV-C light can cause painful skin burns similar to severe sunburn, increasing the risk of skin cancer over time.
Therefore, when operating UV-C devices:
- Never look directly at the light.
- Ensure no humans, pets, or plants are in the room or area being treated.
- Wear appropriate personal protective equipment (PPE), including UV-blocking full-face shields and gloves, if you must be in the vicinity during operation.
- Use timers and remote controls to operate devices from a safe distance.
Material Degradation
Prolonged exposure to UV-C light can also damage certain materials. Plastics can become brittle, colors can fade, and some fabrics or rubbers may degrade over time. This is an important consideration, especially when using UV-C in living spaces or on valuable items.
Conclusion
So, how long does it take for UV light to kill mold? The answer, as we’ve explored, is nuanced. It’s not an instant zap. For airborne mold spores, UV-C in HVAC systems provides continuous inactivation, leading to reduced concentrations over time. For surface mold, high-intensity, direct, and prolonged exposure (minutes to hours) is needed, but only for the exposed layer. UV light cannot penetrate surfaces to kill hidden mold.
UV-C light is a powerful germicidal tool, making it an excellent supplementary measure for mold control. It’s highly effective for keeping HVAC coils clean and reducing airborne mold spores, thereby preventing new growth and improving air quality. However, it is not a magic bullet for existing, visible mold infestations, especially those embedded in porous materials. For significant mold problems, physical removal by qualified professionals remains the gold standard.
Always prioritize safety when considering UV-C light for mold control. Its benefits are substantial, but its powerful nature demands respect and stringent adherence to safety protocols. Used wisely and in conjunction with proper cleaning and moisture control, UV light can be a valuable ally in your ongoing battle against mold.
🎥 Related Video: Does UV light kill mold?
📺 Matt Kelly
This video is from my mold Facebook group: https://www.facebook.com/groups/toxicmoldanswers To test your home and body for …
Frequently Asked Questions
Is UV light safe to use around children or pets for mold?
No, UV-C light is extremely harmful to living beings. Direct exposure can cause severe eye damage and skin burns to children, adults, and pets. Always ensure no living beings are present in the area when a UV-C lamp is operating and follow all safety instructions rigorously.
Does UV light prevent mold from growing back?
UV light can help prevent mold from growing back by continuously inactivating airborne spores and preventing growth on surfaces like HVAC coils. However, it won’t prevent mold if the underlying moisture problem isn’t resolved. Mold will return if there’s a constant source of moisture.
Can I build my own UV light system to kill mold?
It is not recommended to build your own UV light system for mold control due to the significant safety risks and the specific requirements for effective germicidal UV-C. Improperly designed or installed systems can be dangerous and ineffective. Always use professionally designed and certified products.
What type of UV light kills mold?
The type of UV light that kills mold is specifically UV-C (ultraviolet-C). This short-wave, high-energy light is germicidal, meaning it has the ability to damage the DNA and RNA of microorganisms like mold, preventing them from reproducing and rendering them harmless.
Will UV light penetrate surfaces like drywall or wood to kill mold?
No, UV-C light has extremely poor penetration capabilities. It cannot penetrate opaque materials such as drywall, wood, paint, or fabric. Therefore, UV light will only kill mold that is directly exposed on the surface and will not affect mold hidden or embedded within these materials.
Should I clean the mold before using UV light?
Yes, absolutely. For UV light to be effective against surface mold, the area must be clean. Any dust, dirt, or debris on the mold or surface will block the UV-C rays, preventing them from reaching and inactivating the mold. Always physically clean the surface first for best results.